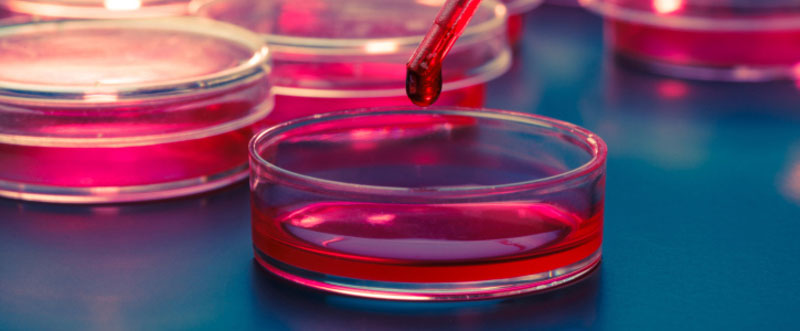
que es un analisis titulometrico 02

Cuando realizamos una valoración, determinamos de manera cuantitativa una sustancia, que se suele llamar, analito, basándonos generalmente en la cantidad que necesitamos de reactivo, de concentración, la cual conoceremos, para hacer reaccionar de manera total el analito en cuestión.
Dependiendo de la forma en la que midamos las cantidades de reactivos, podremos clasificar las valoraciones en tres tipos diferentes:
Para poder llevar a cabo un análisis de tipo volumétrico, que nos permita conocer un analito, se deben cumplir una serie de condiciones como por ejemplo, que exista una reacción química entre el analito y otro tipo de sustancia, la cual puede ser o no un reactivo, que se encuentre bien desplazada hacia la derecha y de la cual conozcamos bien su estequiometría.
Otra de las condiciones indispensables es la de disponer de una disolución de la cual conozcamos la concentración del reactivo. Y por último, debemos tener alguna forma de saber que la reacción entre el analito y el reactivo se haya completado, es decir, debemos tener presente algún tipo de indicador que nos comunique el final del proceso.
También es importante disponer del instrumental de medida. Estos suelen ser materiales de vidrio, que miden volumen y se encuentran graduados, como por ejemplo es el caso de la pipeta, probeta, matraz erlenmeyer y el vaso de precipitados.
Cuando queremos medir volúmenes de manera exacta, o al menos con la mayor exactitud posible, se pasa a utilizar un material aforado, como por ejemplo, el matraz aforado, la pipeta aforada o la bureta.
En los laboratorios, se utilizan otros materiales útiles de vidrio, de los cuales, algunos nos permiten realizar mediciones pero de maneras menos exactas. Entre el material graduado que miden volúmenes con cierta precisión, tenemos por ejemplo, la pipeta graduada, la probeta, distintos matraces erlenmeyer, así como los tan útiles, vasos de precipitados.
El análisis volumétrico, recibe también otros nombres como por ejemplo, análisis titulométrico, aunque es una denominación en desuso, pero en el Diccionario de la Real Academia de la lengua española, se acepta el término “título”, así como también, “Valoración cuantitativa de una disolución”, para hacer referimiento a una volumetría.
310 545 5350 - Cotizaciones
Cr 27 C # 68-79 Barrio Alcázares
Bogotá - Colombia
Calidad Microbiológica
Atención WhatsApp
¿En qué te podemos asistir?.
08:00